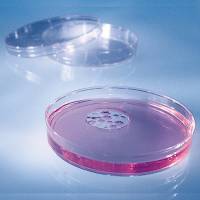

|
Кат. № |
Описание |
|
027-200200 |
Петри Ø 90, h 14мм, асептични, прозрачен полистирен |
|
027-200209 |
Петри Ø 90, h 14мм, стерилни, прозрачен полистирен |
|
027-200202 |
Петри Ø 90, h 14мм, асептични, прозрачен полистирен, с 2 сектора |
|
027-200203 |
Петри Ø 90, h 14мм, асептични, прозрачен полистирен, с 3 сектора |
|
00200201.B |
Петри Ø 50, h 14мм, стерилни, прозрачен полистирен |
|
027-200218 |
Rodac петри /контактни плаки /, Ø 65, h 14.7мм, стерилни, с разграфено дъно
|
|
027-0H-611 |
Поставка за петрита с Ø 90мм и Ø 100мм, размери: 33х21х17,8см материал: полипропилен, автоклавируема 121°C |
|
027-0H-601 |
Кошница за петрита с диаметър до 100мм от неръждаема стомана, за 20бр петрита размери: 21,5х10,5х25см |